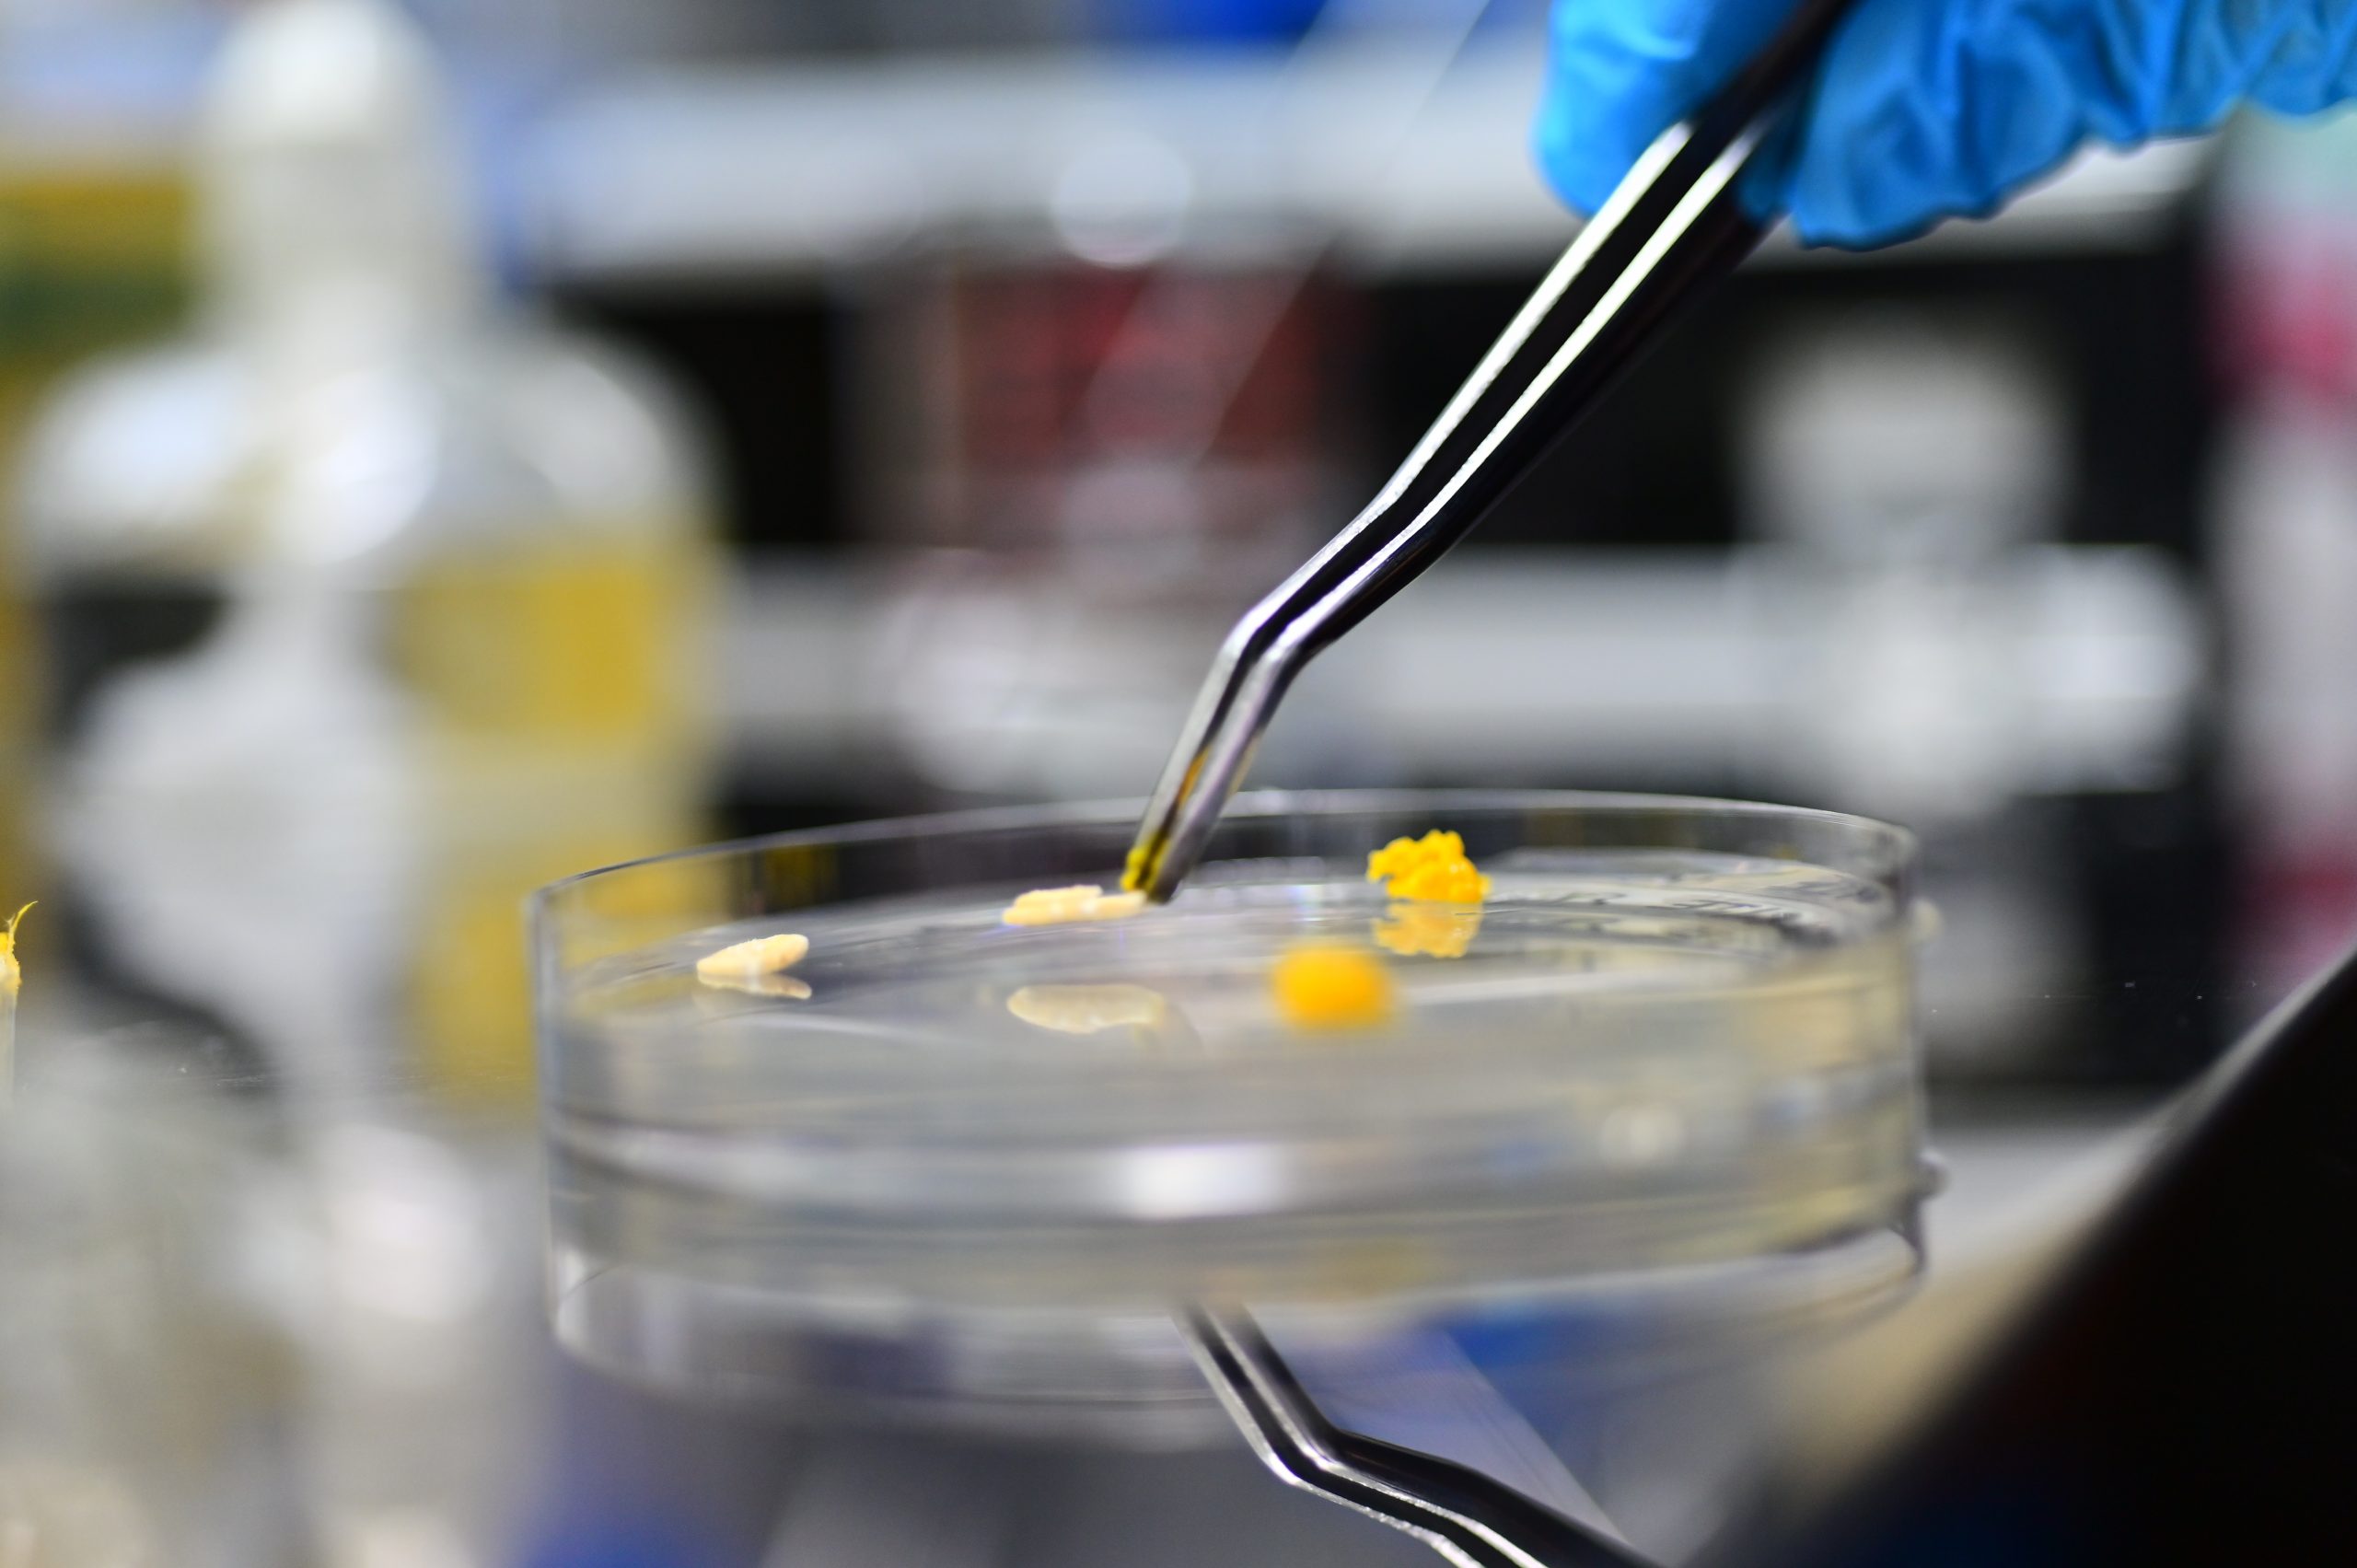
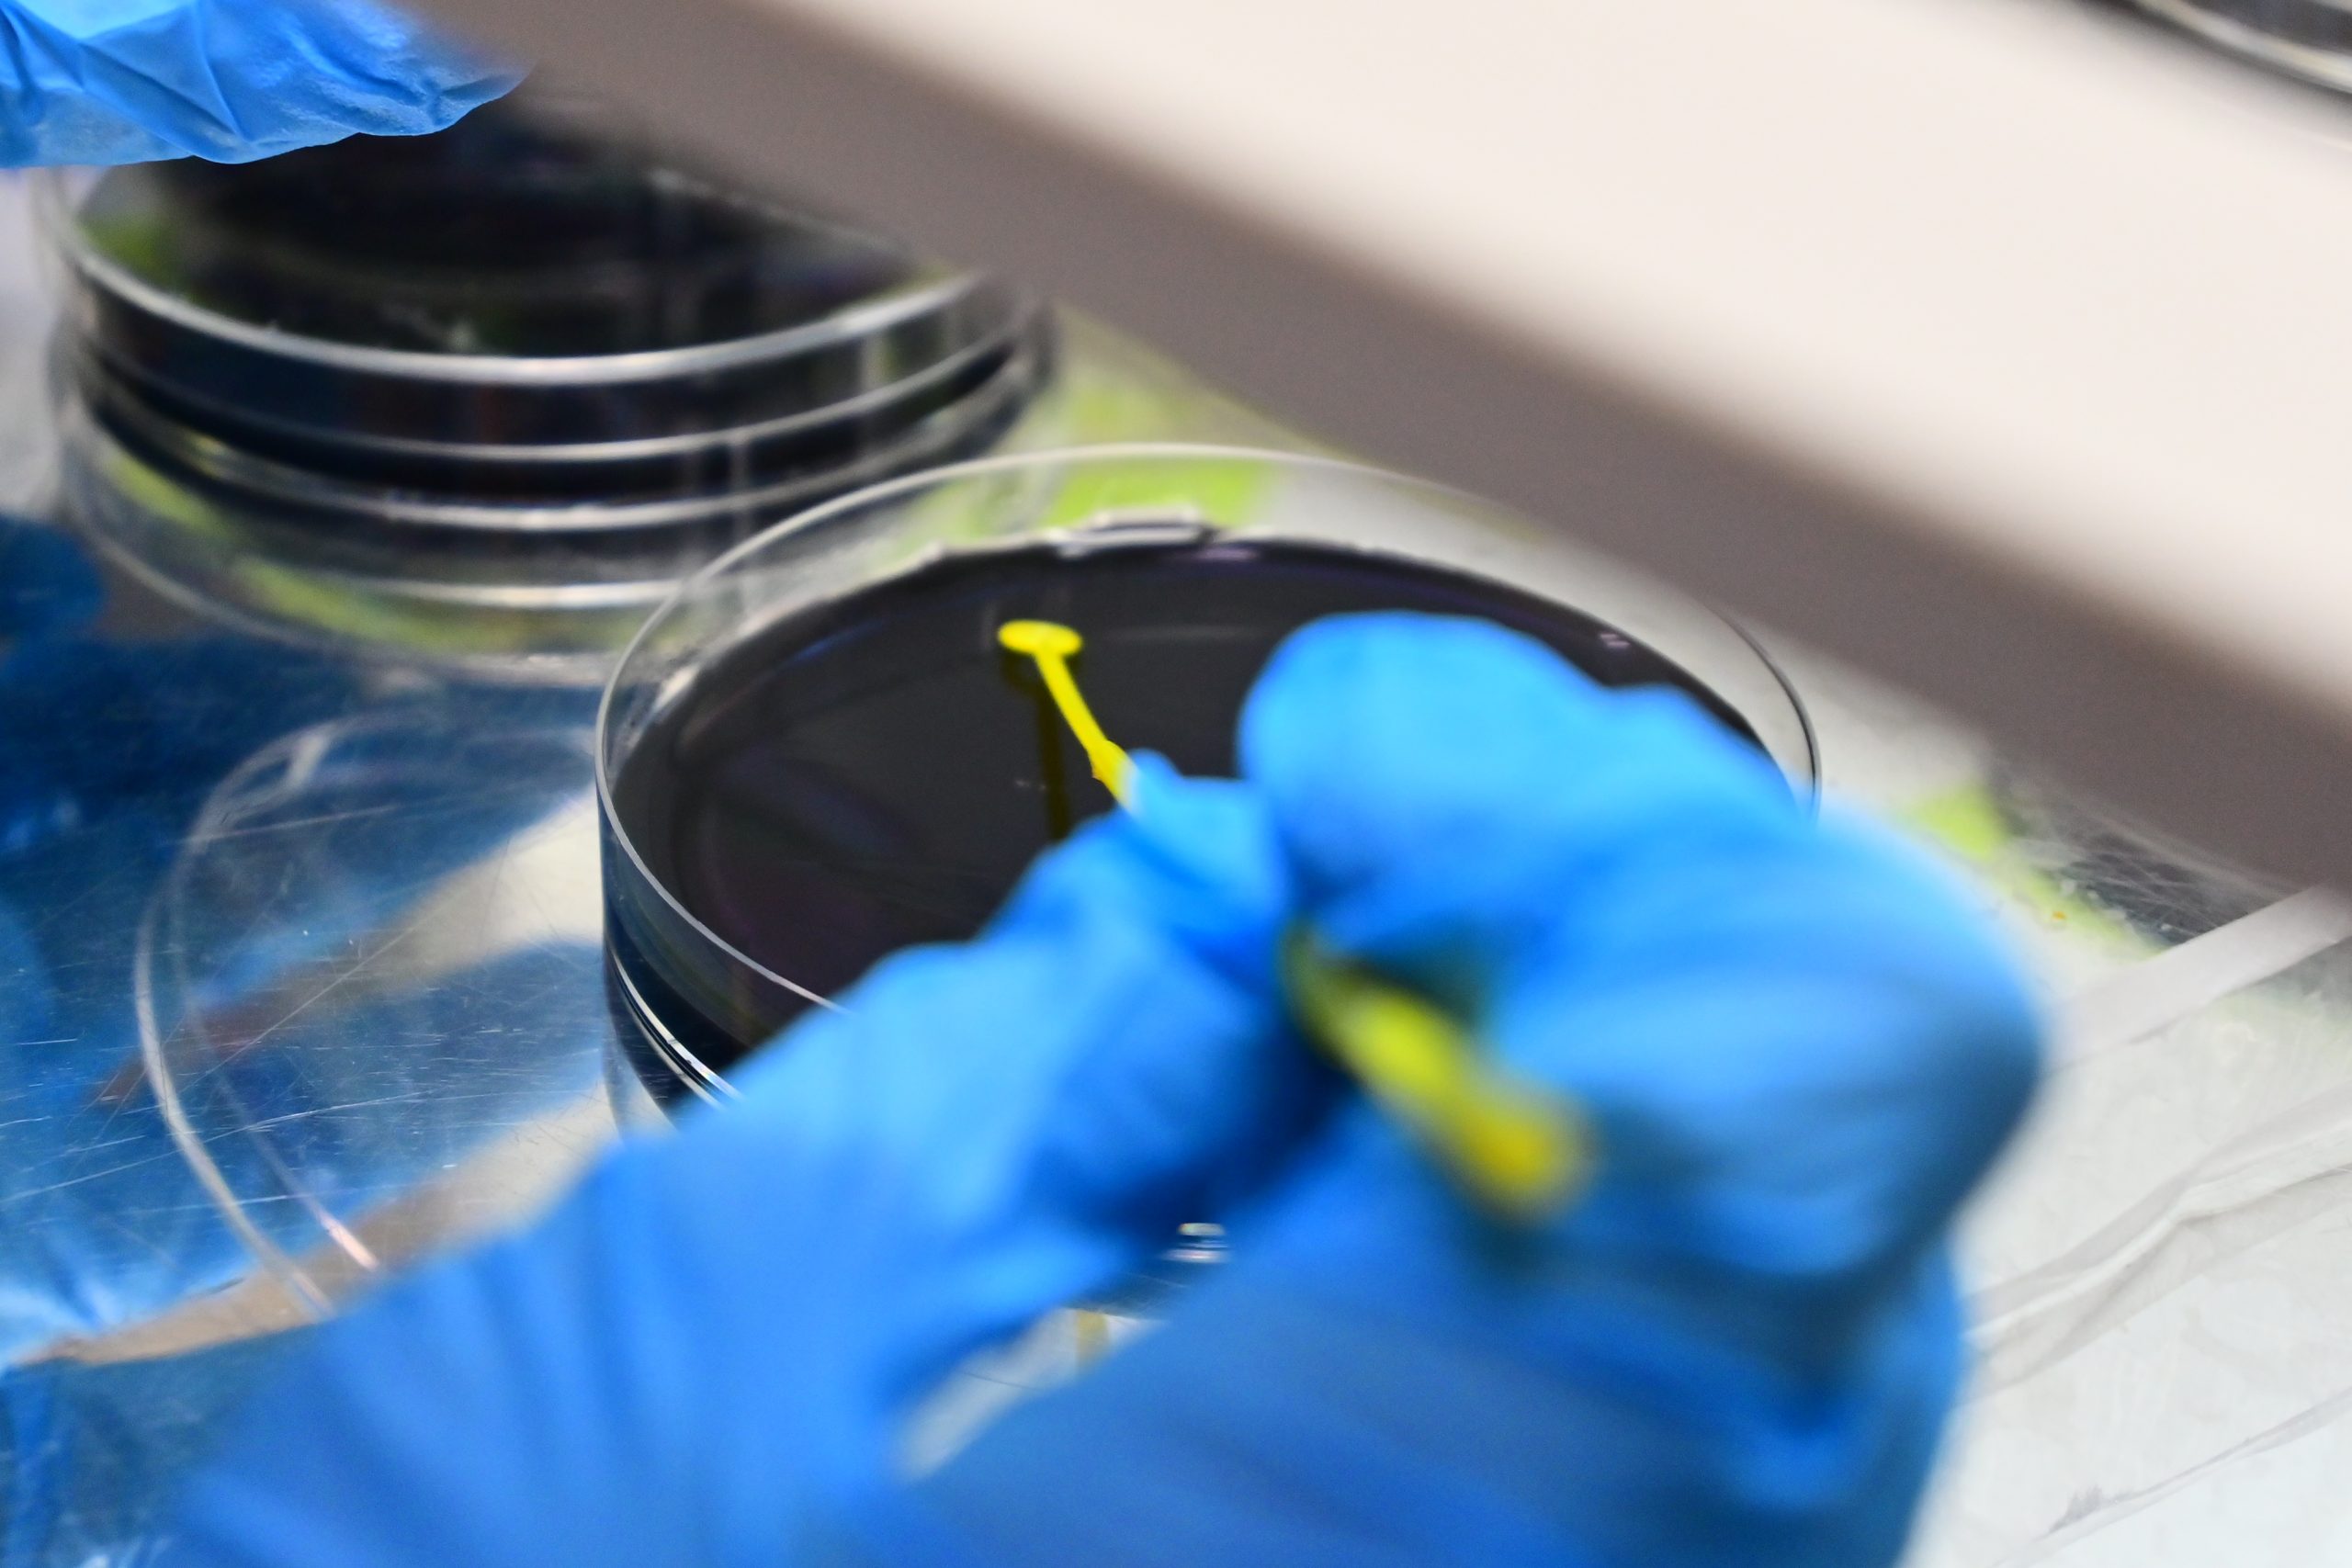

Hands-on
- #Finished

Intra-action and more-than human perspectives suggest that entities are constituted by their relationships and entanglements "acting-with" other entities. This talk will discuss personal research on applying natural dye processes and material impermanence to fine art and social practice, exploring how technology can be used to physicalize and emphasize temporal entanglements.
Tuesday March 10th, 2026 @ 7pm
FabCafe MTRL (2nd Floor)
Tue, March 10, 2026 UTC+09:00
19:00 – 20:30
What is BioClub Tokyo?
BioClub Tokyo is a community biology lab and bio hackerspace that brings together artists, scientists, makers, and biology enthusiasts for hands-on projects spanning bioart, biodesign, DIY bio, open science hardware, and citizen science. All experience levels welcome.
Every Tuesday, 7–9PM: Weekly talks, workshops, and open lab time.
This month’s highlights:
This month’s talk, With-Slowness: Natural Dyes and the Aesthetics of Care by Cat Liu, takes a closer look at natural dyeing not just as a technique but as a practice of attention. What does it mean to work at the pace of plants, bacteria, and fermentation? What kind of knowledge lives in slow processes, and how do we carry it forward?
Later this month, hands-on bacterial dye demonstrations during our open house offer a chance to work directly with pigment-producing microorganisms, exploring color, biology, and material process at the bench.
With-Slowness: Natural Dyes and the Aesthetics of Care by Cat Liu
This work focuses on both the chemical processes that indicate these relationships and fragments of cultural knowledge that are imbedded in material and technology. This introduction to Cat’s work has provided the groundwork to their upcoming research at BioClub.


Basin, 2019
Copper and steel plates inlaid in overbeaten abaca paper; logwood dye
Sculptures investigating the repurposing of old printmaking matrices. Inked etching plates made of steel and copper were embedded in between two freshly formed sheets of overbeaten abaca paper and naturally dyed.
12” x 16”


Souvenir, 2019
Copper and steel plates inlaid in overbeaten abaca paper; logwood dye
An installation investigating the pursuit of memories and escapism through objects, Plasma cut plates made of steel were embedded in between two freshly formed sheets of overbeaten abaca paper dyed with various amounts of logwood.
2’ x 5’

Ongoing Research
Current investigations in printing methods using ink made of natural dyes as a means of approaching non-toxic printmaking in a way that is unique to non-toxic media.
- Those interested in natural dye processes and material impermanence in art practice.
- Those interested in more-than-human and intra-action perspectives on materiality.
- Those interested in speculative design and future crafts.
- Those interested in how cultural knowledge is embedded in materials and technology.
-
Cat Liu
Cat Liu (they/any) is an artist who uses kinetic sculpture, book forms, printing, and handmade paper to explore invisibility, escapism, and secret identities. Their work is grounded in material-based research, with a particular focus on surface, ecological processes, embedded forms of communication, and how materials become carriers of cultural, chemical, and environmental specificity.
Cat received a Master of Fine Arts in Book Arts at the University of Iowa Center for the Book in 2019. They also receive two University of Iowa Graduate College Summer Fellowship grants, a University of Iowa Stanley Graduate Research Grant, and a Fulbright research grant to study dyeing, printing, papermaking practices in China and Japan. Through these experiences, they became interested in how visible reactions of natural dyes form the basis of a sensory language.
Currently, Cat is based in Tokyo, Japan, researching tangible computing with Keio University Graduate School of Media Design’s Future Crafts Lab. There, they are exploring how combining aizome, papermaking, speculative design, and cultural nostalgia can be means of reskilling and regaining cultural agency.
Cat Liu (they/any) is an artist who uses kinetic sculpture, book forms, printing, and handmade paper to explore invisibility, escapism, and secret identities. Their work is grounded in material-based research, with a particular focus on surface, ecological processes, embedded forms of communication, and how materials become carriers of cultural, chemical, and environmental specificity.
Cat received a Master of Fine Arts in Book Arts at the University of Iowa Center for the Book in 2019. They also receive two University of Iowa Graduate College Summer Fellowship grants, a University of Iowa Stanley Graduate Research Grant, and a Fulbright research grant to study dyeing, printing, papermaking practices in China and Japan. Through these experiences, they became interested in how visible reactions of natural dyes form the basis of a sensory language.
Currently, Cat is based in Tokyo, Japan, researching tangible computing with Keio University Graduate School of Media Design’s Future Crafts Lab. There, they are exploring how combining aizome, papermaking, speculative design, and cultural nostalgia can be means of reskilling and regaining cultural agency.
-
18:45
-
Doors open
-
19:00
-
Introduction
-
19:10
-
Presentation (Cat Liu)
・Introduction of practice and current pursuits at BioClub
・* Conducted in English -
19:40
-
Q&A and Discussion
-
20:15
-
Close
-
Date & Time
-
Tue, March 10, 2026 19:00 – 20:30 UTC+09:00
-
Venue
-
FabCafe MTRL
東京都渋谷区道玄坂1-22-7 道玄坂ピア2F
京王井の頭線 神泉駅 南口 徒歩3分
JR 渋谷駅 徒歩10分
03-6416-9190
View on Google Map -
Fee
-
Free
-
Capacity
-
30
-
Organizers & Sponsors
-
Organizers and Sponsors: BioClub, FabCafe